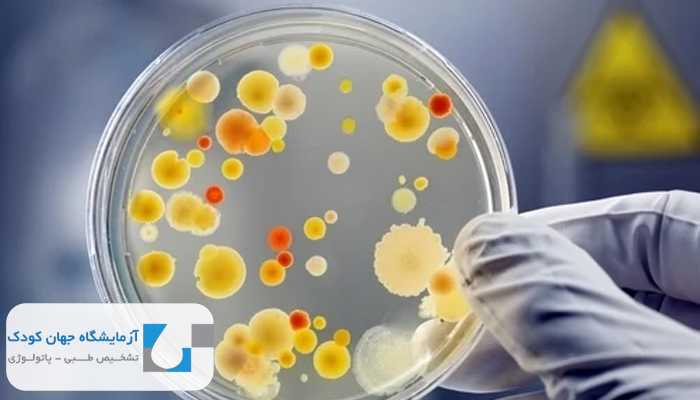
اهمیت میکروب شناسی

میکروب شناسی شاخهای حیاتی از علوم زیستی است که به مطالعه جانداران ریز و میکروسکوپی مانند باکتریها، ویروسها، قارچها و انگلها میپردازد. این علم نقش محوری در درک مکانیسم بروز بیماریهای عفونی، توسعه داروهای ضد میکروبی، ساخت واکسنها و حتی حفظ تعادل میکروبی بدن ایفا میکند. امروزه، میکروبشناسی نهتنها در آزمایشگاههای تشخیص طبی، بلکه در حوزههایی همچون صنایع غذایی، داروسازی، بهداشت عمومی و پژوهشهای مولکولی نیز کاربرد گستردهای دارد. با پیشرفت فناوریهای تشخیصی و ژنتیکی، این حوزه به یکی از پایههای کلیدی در پزشکی مدرن تبدیل شده است. با آزمایشگاه جهان کودک همراه باشید تا با آن آشنا شوید.
میکروب شناسی چیست و چرا اهمیت دارد؟
میکروب شناسی علمی است که به بررسی میکروارگانیسمها یا جانداران میکروسکوپی مانند باکتریها، ویروسها، قارچها، آغازیان و انگلها میپردازد. این موجودات بسیار کوچک، با وجود اندازه ناچیزشان، تاثیرات گستردهای بر سلامت انسان، جانوران، گیاهان و حتی محیط زیست دارند.
اهمیت میکروبشناسی فراتر از صرفا شناخت عوامل بیماریزا است. این علم نقشی کلیدی در زمینههای مختلفی ایفا میکند از تشخیص و درمان بیماریهای عفونی گرفته تا تولید واکسنها، آنتیبیوتیکها، کنترل عفونتهای بیمارستانی، پایش آلودگیهای زیستمحیطی و حتی درک عملکرد میکروبیوم بدن انسان.
در عصر پزشکی دقیق و سلامت مبتنی بر داده، میکروبشناسی به ابزاری حیاتی برای تصمیمگیریهای درمانی و پیشگیری از گسترش بیماریهای مقاوم به دارو تبدیل شده است. بههمین دلیل، حضور این علم در آزمایشگاههای تشخیص طبی مانند آزمایشگاه جهان کودک، مراکز تحقیقاتی و واحدهای کنترل عفونت، کاملا اجتنابناپذیر است.
انواع میکروارگانیسمها در میکروبشناسی
در میکروبشناسی، میکروارگانیسمها یا جانداران میکروسکوپی به گروههای مختلفی تقسیم میشوند که هرکدام ساختار، رفتار زیستی و نقش متفاوتی در سلامت یا بیماری دارند. چهار گروه اصلی عبارتاند از: باکتریها، ویروسها، قارچها و انگلها. شناخت دقیق این موجودات برای تشخیص، درمان و پیشگیری از بیماریهای عفونی کاملا ضروری است که به شرح زیر میباشد:
۱. باکتریها
میکروارگانیسمهایی تکسلولی و زنده هستند که دارای ساختار سلولی سادهای شامل دیواره، غشای سلولی و مواد ژنتیکی مستقلاند. آنها میتوانند بهسرعت تکثیر شوند و بسته به نوعشان، ممکن است مفید (مثل باکتریهای روده) یا بیماریزا (مثل عامل سل) باشند.
۲. ویروسها
ویروسها فاقد ساختار سلولی هستند و خارج از بدن میزبان نمیتوانند زندگی یا تکثیر کنند. آنها تنها از یک کپسید پروتئینی و ماده ژنتیکی (DNA یا RNA) تشکیل شدهاند. ویروسها عامل بیماریهایی مانند آنفلوآنزا، کرونا و HIV هستند و برای تکثیر باید وارد سلول زنده شوند.
۳. قارچها
این گروه شامل میکروارگانیسمهای یوکاریوتی است که ممکن است تکسلولی (مثل کاندیدا) یا پرسلولی (مثل کپکها) باشند. قارچها نسبت به باکتریها ساختار پیچیدهتری دارند و میتوانند باعث عفونتهای سطحی مانند برفک دهان یا عفونتهای عمقی در بیماران با ایمنی پایین شوند.
۴. انگلها
انگلها موجوداتی هستند که برای ادامه زندگی به بدن میزبان وابستهاند. برخی انگلها مانند آمیبها میکروسکوپیاند، در حالیکه برخی دیگر مانند کرمها با چشم غیرمسلح دیده میشوند. آنها اغلب باعث بیماریهای گوارشی، خونی یا سیستمیک میشوند و با مکانیسمهای خاصی سیستم ایمنی میزبان را دور میزنند.

نقش میکروب شناسی در تشخیص بیماریهای عفونی
میکروب شناسی یکی از ارکان اصلی در تشخیص دقیق بیماریهای عفونی است. این علم با بررسی میکروارگانیسمهای بیماریزا اعم از باکتریها، ویروسها، قارچها و انگلها نقش حیاتی در شناسایی عامل عفونت ایفا میکند. فرایند تشخیص میکروبی معمولا با نمونهبرداری از خون، ادرار، خلط، ترشحات زخم یا سایر مایعات بدن آغاز میشود. در ادامه، از روشهایی مانند رنگآمیزی گرم، کشت میکروبی، تستهای بیوشیمیایی، آنتیبیوگرام، و تکنیکهای پیشرفتهای نظیر PCR یا الایزا برای شناسایی دقیق نوع میکروب و حساسیت آن نسبت به داروها استفاده میشود.
اهمیت این تشخیصها در آن است که درمان بیماریهای عفونی بدون شناخت دقیق عامل بیماریزا میتواند ناکارآمد یا حتی خطرناک باشد. بهویژه در دوران افزایش مقاومت آنتیبیوتیکی، میکروبشناسی بالینی به پزشکان کمک میکند تا داروی مناسب را انتخاب کرده و از مصرف بیرویه یا نادرست آنتیبیوتیکها جلوگیری کنند. بهعبارتی، میکروبشناسی پلی است میان تشخیص علمی و درمان هدفمند، و بدون آن، مدیریت موثر بیماریهای عفونی ممکن نیست.
تفاوت بین باکتری، ویروس، قارچ و انگل از دیدگاه میکروب شناسی
به طور کلی تفاوت بین آنها به شرح زیر است:
- ساختار: ویروسها سادهترین ساختار را دارند در مقابل، قارچها و انگلها پیچیدهتر و یوکاریوتیاند.
- توانایی تکثیر: باکتریها، قارچها و انگلها میتوانند مستقل تکثیر شوند، اما ویروسها وابسته به میزباناند.
- پاسخ درمانی: برای باکتریها آنتیبیوتیک، برای قارچها داروهای ضدقارچ، برای انگلها داروهای ضدانگل و برای ویروسها داروهای ضدویروس بهکار میرود.
- محل اثر: باکتریها و ویروسها اغلب بافت خاصی را هدف میگیرند در حالیکه انگلها ممکن است چندین اندام را درگیر کنند.
روشهای نمونهگیری و آزمایش در میکروب شناسی بالینی
در میکروبشناسی بالینی، اولین و مهمترین گام برای تشخیص دقیق بیماریهای عفونی، نمونهگیری صحیح و اصولی از محل احتمالی عفونت است. انتخاب نوع نمونه، روش جمعآوری و شرایط نگهداری آن، مستقیما بر دقت نتیجه آزمایش تاثیر میگذارد. پس از نمونهگیری، از مجموعهای از تکنیکهای تخصصی برای شناسایی عامل میکروبی استفاده میشود.
✅ روشهای متداول نمونهگیری شامل:
- نمونه خون: برای تشخیص باکتریمی، سپسیس و عفونتهای سیستمیک.
- ادرار: در بررسی عفونتهای ادراری.
- نمونه خلط، ترشحات حلق یا بینی: برای عفونتهای تنفسی.
- زخم و ترشحات پوستی: جهت بررسی عفونتهای موضعی یا جراحی.
- نمونه مدفوع: در ارزیابی عفونتهای گوارشی و انگلها.
- مایعات بدن (CSF، پلور، سینوویال): برای تشخیص مننژیت، آبسه، یا عفونتهای مفصلی.
بیشتر بخوانید: آزمایش ادرار
✅ روشهای آزمایشگاهی رایج در میکروبشناسی بالینی:
- کشت میکروبی: نمونه در محیط کشت مناسب قرار داده میشود تا میکروارگانیسمها رشد کرده و شناسایی شوند. این روش پایه اصلی در تشخیص باکتریها و قارچهاست و اغلب با تست حساسیت دارویی (آنتیبیوگرام) همراه است.
- رنگآمیزی (مانند گرم و زیل نیلسن): با استفاده از رنگهای خاص، ساختار سلولی میکروبها قابل مشاهده میشود. این مرحله ابتدایی، به تفکیک باکتریهای گرم مثبت و منفی یا شناسایی باسیلهای مقاوم به اسید کمک میکند.
- تستهای بیوشیمیایی: از طریق واکنشهای آنزیمی و شیمیایی، نوع میکروب با دقت بالاتری تعیین میشود. این روش برای شناسایی باکتریها بسیار کاربرد دارد.
- آزمایشهای ایمونولوژیک (مثل الایزا): برای شناسایی آنتیبادیها یا آنتیژنهای اختصاصی ویروسی و باکتریایی، بسیار حساس و دقیق هستند.
- PCR و روشهای مولکولی: در این روشها، ماده ژنتیکی میکروارگانیسم بهصورت اختصاصی شناسایی میشود. PCR بهویژه در مواردی با تعداد میکروب کم یا در عفونتهای ویروسی بسیار کاربردی است.
- میکروسکوپ الکترونی یا فلورسانس: برای مشاهده دقیقتر ساختارهای میکروبی، بهویژه در ویروسها یا قارچهای خاص استفاده میشود.

مقاومت آنتیبیوتیکی و چالشهای آن در میکروب شناسی
مقاومت آنتیبیوتیکی یکی از بزرگترین چالشهای عصر حاضر در حوزه پزشکی و میکروبشناسی است. این پدیده زمانی رخ میدهد که باکتریها در برابر داروهایی که زمانی بهراحتی آنها را از بین میبردند، مقاوم میشوند. در نتیجه، درمان عفونتهای ساده به کابوسی درمانناپذیر بدل میشود، بهویژه در بیمارستانها و مراکز درمانی با مصرف بالای آنتیبیوتیک.
چرا مشکل مقاومت آنتی بیوتیکی در میکروبشناسی اهمیت دارد؟
در آزمایشگاه میکروبشناسی، تشخیص صحیح نوع باکتری و بررسی الگوی مقاومت آنتیبیوتیکی آن (از طریق تست آنتیبیوگرام)، یکی از مراحل کلیدی درمان دقیق است. بدون این بررسی، پزشک ممکن است آنتیبیوتیکی تجویز کند که نهتنها موثر نیست، بلکه باکتری را مقاومتر نیز میکند.
عوامل اصلی مقاومت آنتیبیوتیکی
عوامل به شرح زیر توضیح داده شده است:
- مصرف خودسرانه یا بیشازحد آنتیبیوتیکها.
- قطع زودهنگام دوره درمان.
- استفاده گسترده از آنتیبیوتیک در دامپروری و کشاورزی.
- انتقال ژنهای مقاوم بین باکتریها از طریق پلاسمیدها.
چالشهای مقاومت در میکروبشناسی بالینی
- کاهش اثربخشی درمانها: بیماران نیاز به درمانهای طولانیتر، داروهای قویتر یا گرانقیمتتری خواهند داشت.
- افزایش هزینههای بهداشتی: بستری طولانیمدت و نیاز به داروهای تخصصی، بار مالی سیستم سلامت را افزایش میدهد.
- خطر شیوع باکتریهای چندمقاومتی (MDR): برخی باکتریها در برابر چندین کلاس دارویی مقاوم میشوند، مانند سودوموناس مقاوم یا MRSA.
- محدود شدن گزینههای درمانی در عفونتهای بیمارستانی: بسیاری از عفونتهای بیمارستانی، بهویژه در بیماران دارای ایمنی پایین، به سختی قابل درمان میشوند.
بیشتر بخوانید: هرمون شناسی
نقش میکروبیوم در سلامت و بیماری انسان
میکروبیوم به مجموعه گستردهای از میکروارگانیسمها شامل باکتریها، ویروسها، قارچها و سایر جانداران میکروسکوپی گفته میشود که بهطور طبیعی در بدن انسان به ویژه در روده، پوست، دهان و دیگر نواحی زندگی میکنند. این جامعه پیچیده و پویا، نقش بیبدیلی در حفظ تعادل زیستی و سلامت بدن ایفا میکند.
در حالت طبیعی، میکروبیوم با تقویت سیستم ایمنی، کمک به هضم غذا، تولید ویتامینها و جلوگیری از رشد میکروبهای بیماریزا، زمینه سلامت عمومی را فراهم میآورد. اما هرگونه اختلال در تعادل این جمعیت میکروبی، که اصطلاحا (دیسبیوز) نامیده میشود، میتواند زمینهساز بیماریهای متعددی از جمله عفونتهای گوارشی، التهابهای مزمن، بیماریهای خودایمنی، آلرژیها و حتی اختلالات روانی شود.
مطالعات جدید نشان دادهاند که میکروبیوم نه تنها در سلامت دستگاه گوارش بلکه در سلامت متابولیک، قلبی-عروقی، و حتی عملکرد مغز نقش دارد. بنابراین، حفظ تعادل میکروبیوم از طریق رژیم غذایی مناسب، پرهیز از مصرف بیرویه آنتیبیوتیکها و سبک زندگی سالم، به عنوان یکی از اولویتهای حفظ سلامت مطرح شده است.
نتیجه گیری
میکروبشناسی علمی است که دنیای میکروارگانیسمها را شناخته و در تشخیص و درمان بیماریهای عفونی نقش حیاتی دارد. پیشرفتهای آزمایشگاهی به بهبود مدیریت درمان و کنترل مقاومت دارویی کمک کردهاند. این علم با شناخت دقیق میکروبها، سلامت عمومی را ارتقا میبخشد. استمرار تحقیقات در میکروبشناسی، راهحلی کلیدی برای مقابله با چالشهای سلامت آینده است.
سوالات متداول
کشت میکروبی به ما امکان میدهد تا عامل بیماریزا را در محیط آزمایشگاهی رشد داده و شناسایی کنیم و بر اساس آن، بهترین درمان را انتخاب کنیم.
PCR تکنیکی مولکولی است که با شناسایی دقیق ماده ژنتیکی میکروبها، به تشخیص سریع و حساس عفونتهای مختلف کمک میکند، حتی زمانی که تعداد میکروبها کم باشد.
رعایت بهداشت فردی، استفاده صحیح از آنتیبیوتیکها، استریل تجهیزات پزشکی و واکسیناسیون موثرترین روشها برای پیشگیری از انتقال عفونتها هستند.
آزمایشهای میکروسکوپی مستقیما ساختار میکروبها را مشاهده میکنند، اما روشهای مولکولی مانند PCR، به شناسایی دقیقتر و سریعتر بر اساس ماده ژنتیکی میپردازند.
میکروبشناسی با تعیین الگوی مقاومت میکروبها و توصیه درمان مناسب، به کاهش مصرف نادرست آنتیبیوتیکها و کنترل گسترش مقاومت کمک میکند.
